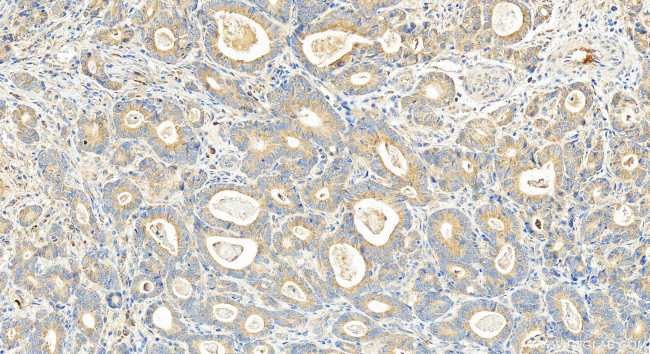
RPS11 Antibody in Immunohistochemistry (Paraffin) (IHC (P))

Search
Proteintech
RPS11 Polyclonal Antibody
{{$productOrderCtrl.translations['antibody.pdp.commerceCard.promotion.promotions']}}
{{$productOrderCtrl.translations['antibody.pdp.commerceCard.promotion.viewpromo']}}
{{$productOrderCtrl.translations['antibody.pdp.commerceCard.promotion.promocode']}}: {{promo.promoCode}} {{promo.promoTitle}} {{promo.promoDescription}}. {{$productOrderCtrl.translations['antibody.pdp.commerceCard.promotion.learnmore']}}
产品信息
15942-1-AP
种属反应
宿主/亚型
分类
类型
抗原
偶联物
形式
浓度
规格
纯化类型
保存液
内含物
保存条件
运输条件
产品详细信息
Immunogen sequence: MADIQTERAY QKQPTIFQNK KRVLLGETGK EKLPRYYKNI GLGFKTPKEA IEGTYIDKKC PFTGNVSIRG RILSGVVTKM KMQRTIVIRR DYLHYIRKYN RFEKRHKNMS VHLSPCFRDV QIGDIVTVGE CRPLSKTVRF NVLKVTKAAG TKKQFQKF
靶标信息
Ribosomes, the organelles that catalyze protein synthesis, consist of a small 40S subunit and a large 60S subunit. Together these subunits are composed of 4 RNA species and approximately 80 structurally distinct proteins. This gene encodes a ribosomal protein that is a component of the 40S subunit. The protein belongs to the S17P family of ribosomal proteins. It is located in the cytoplasm. The gene product of the E. coli ortholog (ribosomal protein S17) is thought to be involved in the recognition of termination codons. This gene is co-transcribed with a small nucleolar RNA gene, which is located in its third intron. As is typical for genes encoding ribosomal proteins, there are multiple processed pseudogenes of this gene dispersed through the genome.
仅用于科研。不用于诊断过程。未经明确授权不得转售。
篇参考文献 (0)
生物信息学
蛋白别名: 40S ribosomal protein S11; RPS 11; Small ribosomal subunit protein uS17; unnamed protein product
基因别名: RPS11; S11; uS17
UniProt ID: (Human) P62280, (Mouse) P62281, (Rat) P62282
Entrez Gene ID: (Human) 6205, (Mouse) 27207, (Rat) 81774